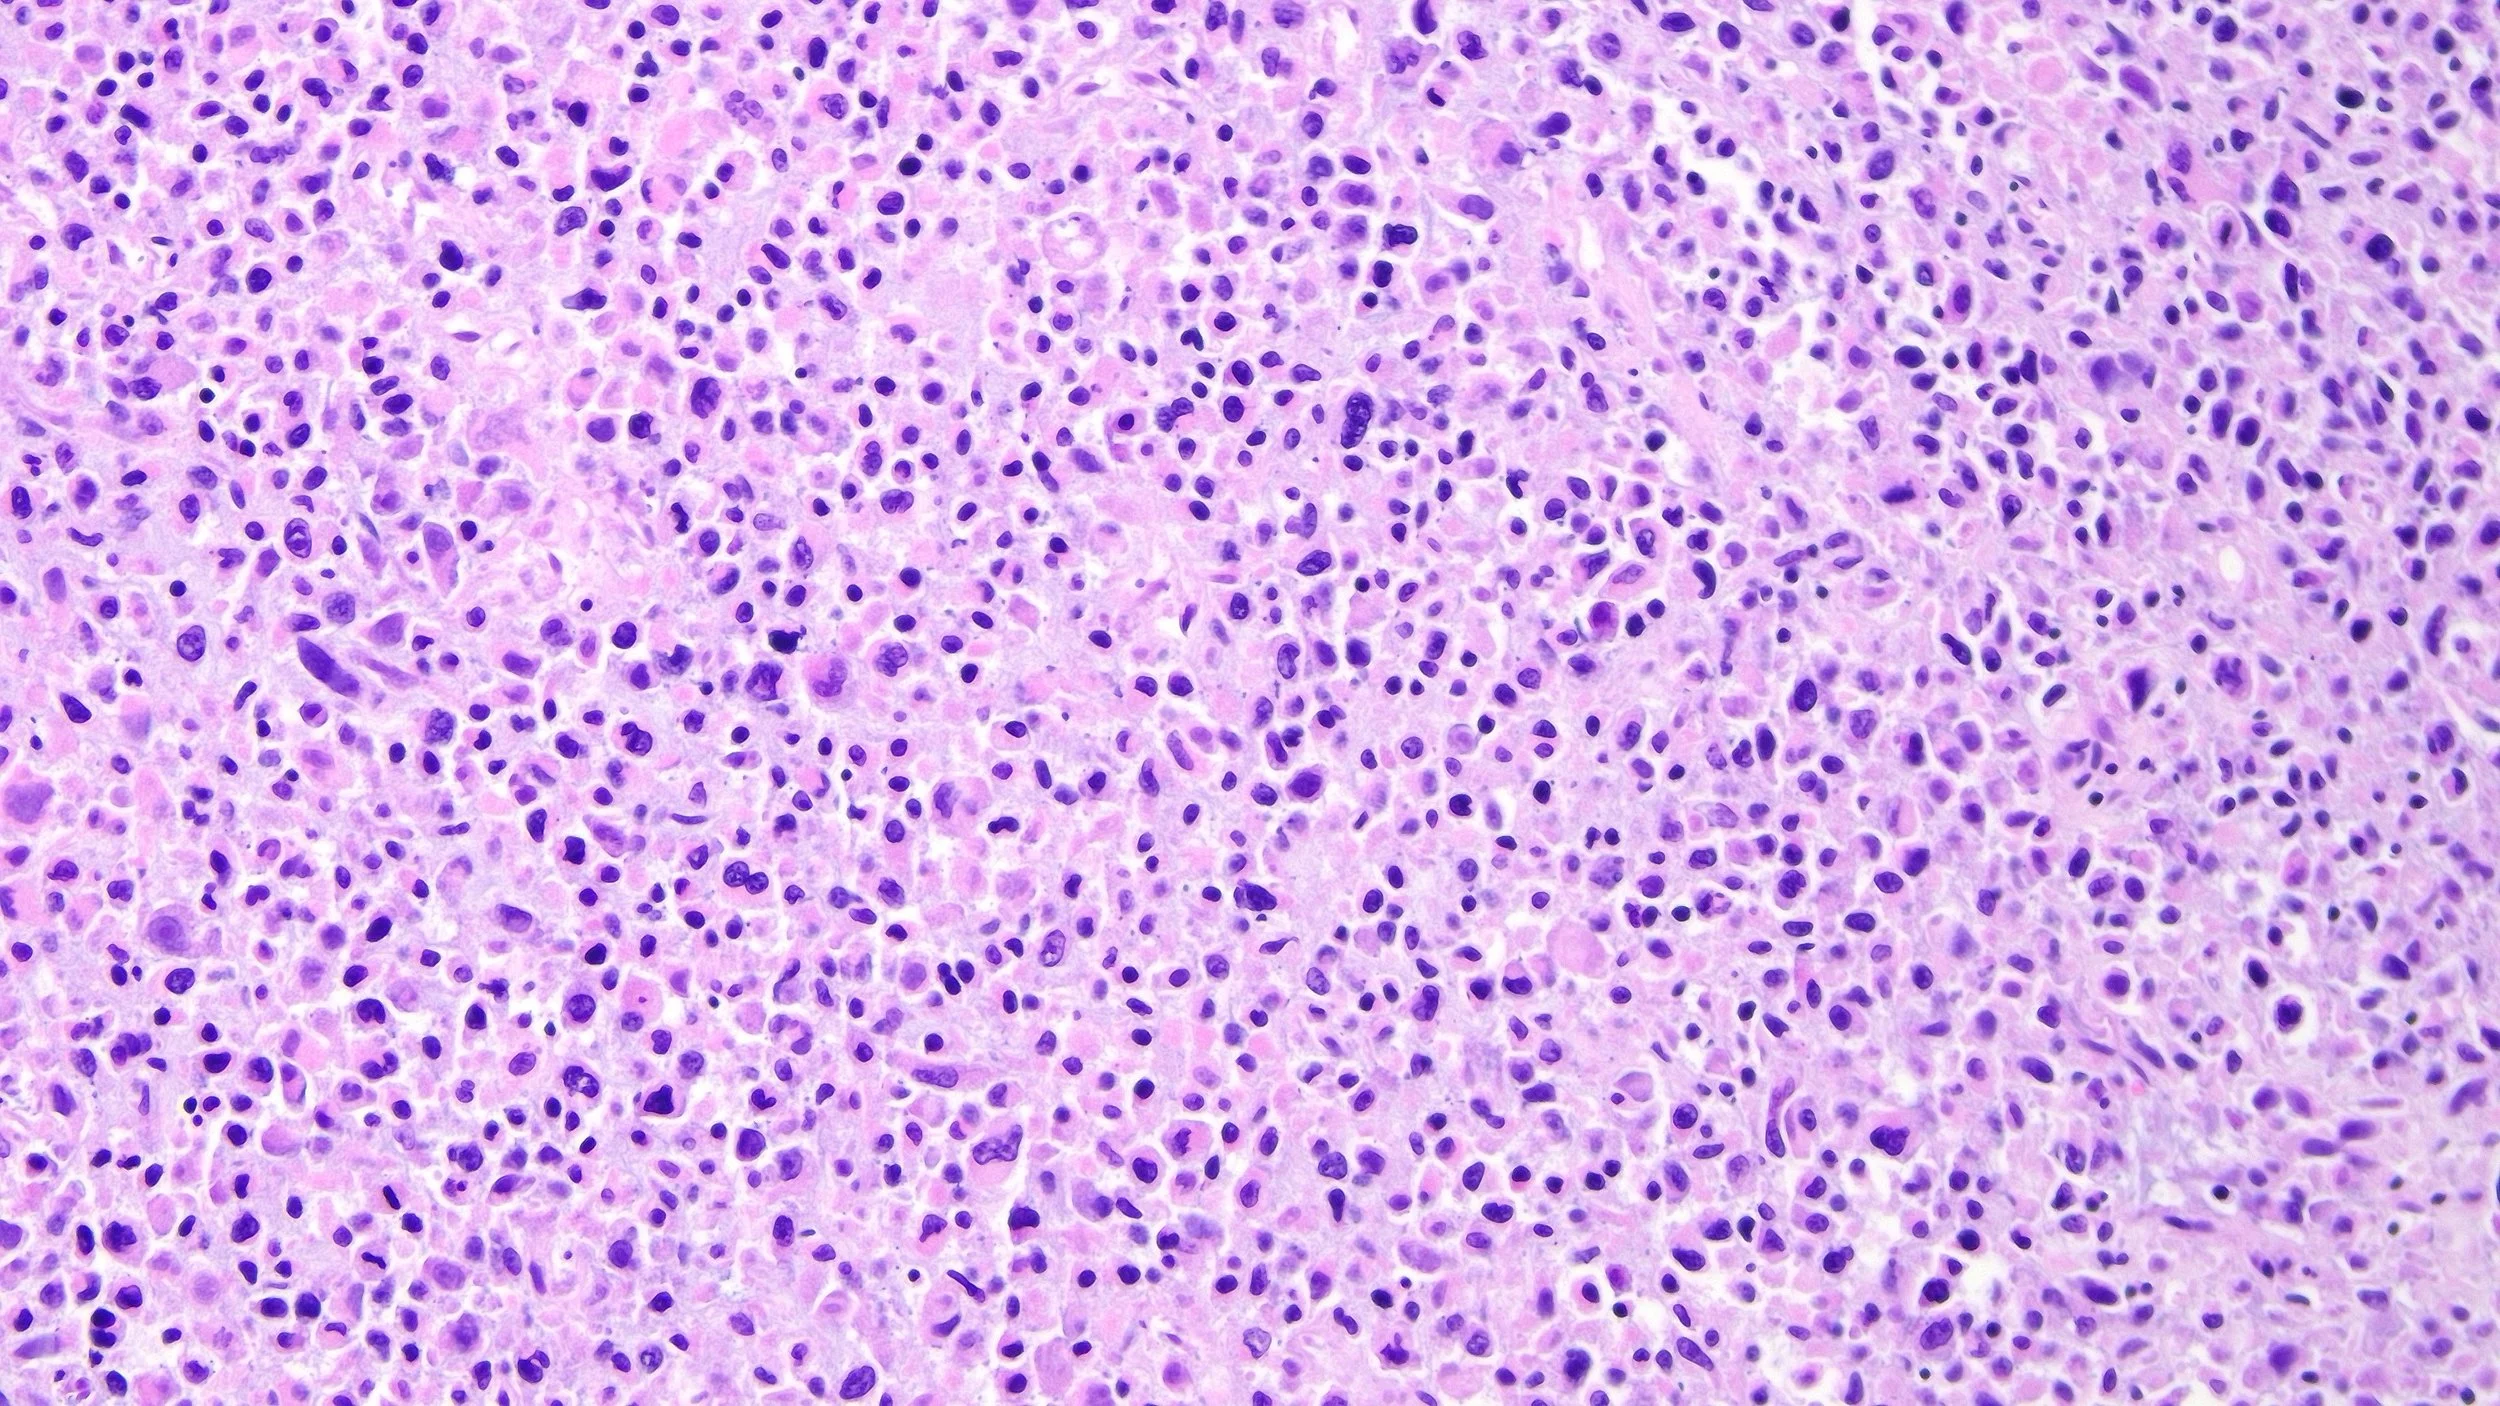

Expert autopsy and legal services
About JHP
Jennifer Hammers Pathology, LLC is a specialized forensic pathology practice led by board-certified forensic, anatomic, and clinical pathologist Dr. Jennifer Hammers, D.O. Serving Western Pennsylvania and the surrounding tri-state area, the practice performs autopsies for Westmoreland, Armstrong, Fayette, Washington, Indiana, and Greene counties. In addition to county-held contracts, the practice conducts autopsies for Independence Health Systems, additional coroner counties, and offers private autopsies for individuals, attorneys, and families seeking further clarification or detailed information regarding a death.
Beyond autopsy services, JHP provides expert medical opinions for legal professionals through comprehensive medicolegal reports, reviews, and courtroom testimonies. Dr. Hammers, supported by her team, has participated in numerous notable cases, underscoring her commitment to justice and the highest standards of forensic investigation.
Education and research are at the very core of JHP. The practice not only advances the field through active involvement in landmark cases but also through participation in establishing best practices and standards, the publication of numerous papers and posters, teaching at seminars and conferences, participating in symposia, and personal continuing education, reflecting the ongoing scholarly contributions of the entire team.



Our Services

We offer thorough, medically driven examinations by a specialized team to determine the cause and manner of death. By carefully analyzing organs, tissues, toxicology, genetics, and other targeted testing, these examinations can reveal critical information that may not be evident from external observation alone. For families, autopsies can offer much-needed clarity by answering lingering questions about their loved one’s passing, providing closure, and uncovering previously unidentified disease processes, hereditary conditions, and public health risks that could impact the future health of the individual and family.

Bridging the gap between medicine and law, Dr. Jennifer Hammers offers expert, impartial medical consulting that transforms complex death investigations into clear, actionable insights. Dr. Hammers and her team leverage decades of experience in forensic pathology, nursing, and related fields to provide precise, evidence-based analysis, helping attorneys, law enforcement, and families understand every critical detail. With a commitment to clarity, integrity, and timely support, we empower our clients to navigate challenging cases with confidence and achieve the justice and closure they deserve. By uncovering the truth, we uncover clarity.

At Jennifer Hammers Pathology, LLC, education is at the heart of everything we do. Dr. Hammers and her dedicated team are passionate about advancing forensic science through active teaching and mentorship. Our experts regularly lead courses for the PA State Coroners Association and the PA State Police, and provide specialized training for law enforcement officers across the nation. We also engage in hands-on training for students studying forensics, law, and medicine, as well as those training to become Pathologists’ Assistants, alongside other industry professionals, through seminars, conferences, job shadowing, and internships.

Former Westmoreland County Coroner Tim Carson
“I’ve had the pleasure of working with Dr. Jennifer Hammers, and her elite forensic pathology group, who have conducted 376 forensic autopsies and scientific support over the past 3 and a half years. She and her staff have provided me and my office with high quality, professional and compassionate care with fast turnaround times. She and her staff are always available to answer any questions, or provide scientific insight of the forensic autopsy findings.”
Bob Fitzsimmons, Wheeling, W.Va.
“I've been practicing personal injury and wrongful death cases for 47 years and I would rate Dr. Hammers as one of the best if not the Best expert I've ever worked with. She reviews and knows the records, she is accessible, she is a great witness in depositions and in court. Dr Hammers explains and teaches difficult medical issues on a level that lawyers and jurors understand and she defends her opinions.”





